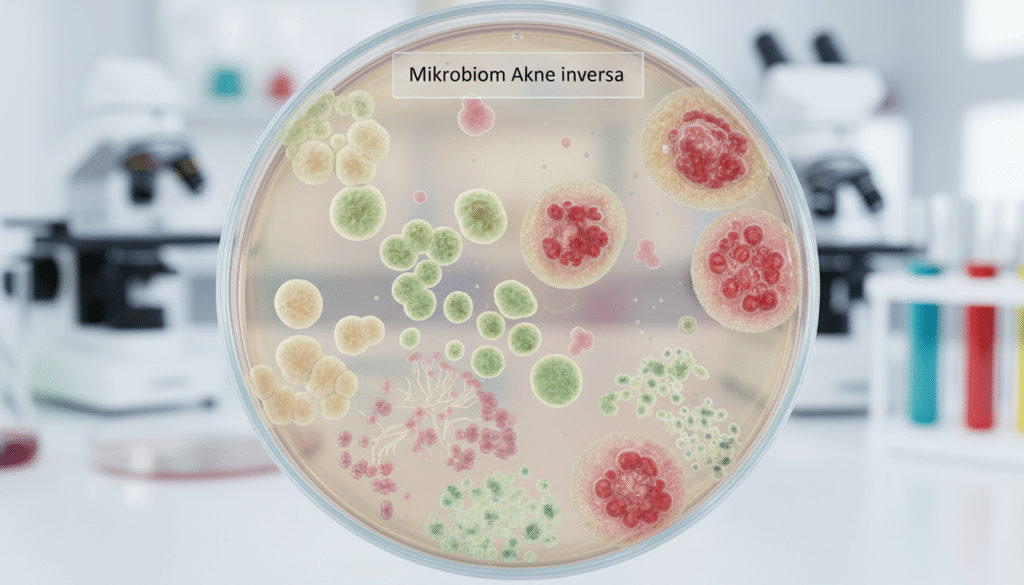
Mikrobiom Akne inversa Mikrobiom Akne inversa

Akne inversa ist keine „normale“ Akne. Es handelt sich um eine chronische Hautentzündung, die tief sitzt und stark schmerzen kann. Viele Betroffene erleben wiederkehrende Knoten, die sich entzünden und aufbrechen.
Wer nach Akne inversa Ursachen sucht, stößt schnell auf viele Halbwahrheiten. Entscheidend ist: Die Hidradenitis suppurativa Entstehung ist ein Zusammenspiel aus verstopften Haarfollikeln, Entzündung und individueller Veranlagung. Dazu kommen HS Auslöser im Alltag, die Schübe wahrscheinlicher machen.
In Akne inversa Deutschland wird die Erkrankung oft spät erkannt, weil sie anfangs wie harmlose Pickel wirkt. Umso wichtiger ist ein klarer Blick auf typische Muster und frühe Warnzeichen. Eine frühe Abklärung in der Dermatologie kann helfen, den Verlauf zu bremsen.
Dieser Artikel ordnet zuerst ein, was Akne inversa von klassischer Akne unterscheidet. Danach geht es um den Mechanismus im Haarfollikel, die Rolle von Drüsen und dem Immunsystem. Außerdem werden Genetik, Hormone, Alltagseinflüsse, das Mikrobiom sowie Frühsymptome und Chronifizierung verständlich erklärt.
Das sind die Top 10 besten Akne inversa Produkte
Akne inversa (Hidradenitis suppurativa): Definition und Abgrenzung zu „normaler“ Akne
Wer Akne inversa zum ersten Mal erlebt, hält die Beschwerden oft für „starke Pickel“. Die Akne inversa Definition beschreibt jedoch eine eigene Erkrankung mit typischem Verlauf. Entscheidend ist, dass die Entzündung tief sitzt, wiederkehrt und den Alltag stark belasten kann.
Was Akne inversa ausmacht: chronisch-entzündliche Erkrankung der Haarfollikel
Im Kern handelt es sich um eine chronische Haarfollikelentzündung. Der Startpunkt liegt am Haarfollikel, nicht an der „oberflächlichen“ Haut wie bei vielen klassischen Unreinheiten. Dadurch entstehen Entzündungsherde, die sich ausbreiten und lange aktiv bleiben können.
Beim Hidradenitis suppurativa Unterschied Akne geht es daher weniger um Mitesser oder einzelne Pusteln. Typisch sind tiefe, druckschmerzhafte Knoten, die in Schüben auftreten. Viele Betroffene berichten, dass Wärme, Reibung und Schwitzen die Beschwerden verstärken.
Typische Körperstellen: Achseln, Leiste, Gesäßfalte, Intimbereich
Die Erkrankung zeigt sich bevorzugt dort, wo Haut auf Haut liegt. Häufig genannt werden die typischen Stellen Achsel Leiste, aber auch Gesäßfalte und Intimbereich. Diese Areale sind oft feucht, werden mechanisch belastet und reagieren empfindlich auf Reibung.
| Merkmal | Akne inversa (HS) | Akne vulgaris |
|---|---|---|
| Typische Lokalisation | Achselhöhlen, Leistenregion, Gesäßfalte, Intimbereich | Gesicht, Rücken, Brust |
| Tiefe der Entzündung | Tief im Gewebe, oft tastbare Knoten | Meist oberflächlicher, Komedonen und Papeln |
| Verlauf | Schubweise, wiederkehrend, kann sich ausdehnen | Häufig phasenweise, oft in der Jugend stärker |
| Typische Folgen | Schmerzhafte Abszesse, mögliche Fistelgänge Narben | Pickelmale, teils Narben bei schweren Formen |
Warum es nicht „nur Pickel“ sind: Knoten, Abszesse, Fistelgänge und Narben
Bei Akne inversa können aus Knoten rasch Abszesse werden, die nässen oder aufplatzen. Mit der Zeit können sich Fistelgänge Narben entwickeln, also tunnelartige Verbindungen unter der Haut und feste Stränge. Das kann Bewegungen schmerzhaft machen, etwa beim Gehen oder beim Heben der Arme.
Weil das Beschwerdebild so anders ist, greifen reine „Pickel-Routinen“ oft zu kurz. Eine klare Einordnung hilft, Scham zu reduzieren und den nächsten Schritt planbar zu machen. Auch Geruch und Sekret können vorkommen, was die Lebensqualität zusätzlich beeinflusst.
Wie entsteht Akne inversa?
Viele Betroffene fragen sich: Wie entsteht Akne inversa im Detail? Der Prozess beginnt oft unauffällig, tief in der Haut, und entwickelt sich dann in mehreren Schritten. Dabei geht es weniger um „Pickel“ an der Oberfläche als um Vorgänge rund um Haarfollikel und umliegendes Gewebe.
Startpunkt im Haarfollikel: Verhornungsstörung und Follikelverschluss
Am Anfang steht häufig eine Verhornungsstörung Haut: Hornmaterial wird nicht wie üblich abgetragen, sondern staut sich. Dadurch verengt sich der Ausführungsgang des Haarfollikels.
Kommt Talg hinzu, entsteht ein Follikelverschluss. Der Inhalt kann schlechter abfließen, der Follikel dehnt sich, und der Druck nimmt zu. Das passiert meist in Arealen mit Reibung und Wärme, wo die Haut zusätzlich belastet ist.
Follikelruptur als Auslöser: Entzündungsreaktion im umliegenden Gewebe
Hält der Druck an, kann die Follikelwand einreißen. Diese Follikelruptur Entzündung ist ein Wendepunkt, weil Bestandteile wie Keratin und Talg ins umliegende Gewebe gelangen.
Dort werden sie als Reiz wahrgenommen. Es folgt eine starke lokale Reaktion: Rötung, Schwellung, Überwärmung und deutlicher Schmerz. Aus dem Knoten kann sich ein Abszess entwickeln, der sich prall anfühlt und tief sitzt.
Chronifizierung: wiederkehrende Schübe, Fisteln und Vernarbung
Wenn Entzündungsherde nicht vollständig abklingen oder erneut aufflammen, entstehen wiederkehrende Schübe. Neue Knoten können neben älteren Stellen auftreten, manchmal in kurzen Abständen.
Mit der Zeit kann das Gewebe umbauen. Typisch sind dann Schübe Fisteln Narben HS: Unter der Haut bilden sich Verbindungsgänge, die immer wieder Sekret abgeben können, und es entstehen feste, derbe Stränge. Narbengewebe kann zudem den Abfluss weiter erschweren und die Region empfindlicher für Druck und Reibung machen.
| Phase | Was im Gewebe passiert | Wie es sich anfühlen oder zeigen kann |
|---|---|---|
| Verhornung und Stau | Verhornungsstörung Haut verengt den Ausführungsgang; Material sammelt sich im Follikel | Spannungsgefühl, kleiner tiefer Knubbel, oft zunächst ohne sichtbare Öffnung |
| Follikelverschluss | Follikelverschluss durch Hornmaterial und Talg; Druck steigt im Follikel | Druckschmerz, zunehmende Schwellung, Haut kann druckempfindlich werden |
| Ruptur und Reaktion | Follikelruptur Entzündung durch austretendes Keratin und Talg im umliegenden Gewebe | Starke Schmerzen, Rötung, Wärme, möglicher Abszess mit pochendem Gefühl |
| Wiederkehr und Umbau | Wiederholte Entzündung mit Gewebsumbau; Gänge und Vernarbungen können entstehen | Schübe Fisteln Narben HS mit wiederkehrendem Nässen, verhärteten Strängen und Narbenzügen |
Welche Rolle spielen Haarfollikel, Talgdrüsen und Schweißdrüsen?
Bei Akne inversa greifen mehrere Faktoren ineinander. Entscheidend ist, wo die Entzündung startet und warum sie in bestimmten Hautzonen immer wieder aufflammt. In okklusive Areale kommt es leichter zu Stau, Wärme und gereizter Haut.
Warum der Haarfollikel im Zentrum steht
Der heutige Blick auf HS rückt den Follikel in den Vordergrund. Haarfollikel Akne inversa beginnt oft mit einem Verschluss im Ausführungskanal. Dadurch baut sich Druck auf, das Gewebe wird anfälliger, und Entzündung kann sich ausbreiten.
Das erklärt auch, warum die Beschwerden nicht zufällig verteilt sind. Gerade in Hautfalten, wo die Haut dicht aufliegt, werden Reize schneller zum Problem.
Talg und Keratin: Bedingungen für Verstopfung und Entzündung
Im Follikel sammeln sich natürliche Hautbestandteile. Talgdrüsen Keratin Pfropf beschreibt dabei das typische Gemisch, das wie ein Stöpsel wirken kann. Bleibt dieses Material stecken, wird der Kanal weiter gedehnt und die Umgebung reagiert empfindlich.
Kommt es zum Aufbrechen der Wand, gelangt Inhalt ins umliegende Gewebe. Das kann eine starke Abwehrreaktion auslösen, auch ohne dass es am Anfang „klassisch“ wie eine Infektion wirkt.
Schweißdrüsen in betroffenen Arealen: Einfluss von Feuchtigkeit und Reibung
Schweißdrüsen HS spielen eher eine verstärkende Rolle als den eigentlichen Startpunkt. In Zonen mit viel Schweiß weicht die Haut leichter auf, die Barriere wird durchlässiger und reagiert schneller gereizt.
Besonders typisch ist Reibung Feuchtigkeit Achsel Leiste: Haut-auf-Haut-Kontakt, Wärme und Bewegung setzen die Region unter Dauerstress. Kleine Scheuerstellen können dann wie ein zusätzlicher Trigger wirken, vor allem in okklusive Areale.
| Struktur | Was sie beiträgt | Typische Folge im Alltag |
|---|---|---|
| Haarfollikel | Neigt zu Verschluss und Druckaufbau; Haarfollikel Akne inversa wird so verständlicher | Empfindliche Knoten nach wiederkehrender Belastung in Hautfalten |
| Talgdrüsen und Keratin | Talgdrüsen Keratin Pfropf kann den Ausführungsgang blockieren und Material stauen | Spannungsgefühl und Reizung, wenn „Stau“ zunimmt |
| Schweißdrüsen | Schweißdrüsen HS erhöhen Feuchte und Wärme, die Haut wird schneller wund | Mehr Irritation bei Hitze, Sport oder langem Sitzen |
| Mechanische Faktoren | Reibung Feuchtigkeit Achsel Leiste fördert Mikroverletzungen und hält Entzündung aktiv | Beschwerden unter enger Kleidung, in Bewegung oder bei langem Reiben |
Entzündungsprozesse und Immunsystem: Was passiert im Körper?
Nach dem Verschluss und der Ruptur eines Haarfollikels startet eine starke Abwehrreaktion. Beim Thema Immunsystem Akne inversa geht es deshalb weniger um „Schmutz“, sondern um ein überaktives Alarmsignal in der Haut. Aus einer kurzen Reaktion kann sich eine chronische Entzündung HS entwickeln, die immer wieder aufflammt.
Vor Ort wandern Abwehrzellen in das Gewebe ein und setzen Botenstoffe frei. Diese Zytokine Hidradenitis suppurativa verstärken Schmerz, Wärme und Schwellung. Wenn sich Flüssigkeit und Zellreste sammeln, kann Eiter entstehen, obwohl das eigentliche Problem tiefer beginnt.
Typisch ist, dass die Entzündung nicht einfach „abschaltet“. Reibung in Hautfalten, Rauchen, Übergewicht oder hormonelle Schwankungen können das Gebiet immer neu reizen. So bleibt die entzündliche Kaskade Haut in Gang, auch wenn ein einzelner Knoten scheinbar schon abklingt.
| Ebene | Was im Körper passiert | Was Betroffene oft bemerken |
|---|---|---|
| Lokal in der Haut | Einwanderung von Immunzellen, Aktivierung von Gefäßen und Gewebe, Verstärkung durch Zytokine Hidradenitis suppurativa | Druckschmerz, Überwärmung, Schwellung, teils nässende Areale |
| Verlängerte Entzündung | Wiederholte Trigger halten die chronische Entzündung HS aktiv, Barriere und Mikrorisse erleichtern neue Reize | Schübe am gleichen Ort, empfindliche Haut, längere Heilungszeiten |
| Über die Haut hinaus | Bei einem Teil der Betroffenen zeigen sich Zeichen einer systemische Entzündung, die ärztlich mitgedacht wird | Allgemeines Krankheitsgefühl, Erschöpfung, zusätzliche Beschwerden möglich |
Dieses Verständnis erklärt, warum Ärztinnen und Ärzte nicht nur auf die Oberfläche schauen. Neben Pflege und Wundmanagement spielen auch Ansätze eine Rolle, die Entzündungswege bremsen. Im Zentrum steht dabei, die systemische Entzündung und die lokale entzündliche Kaskade Haut besser einzuordnen, statt nur einzelne Stellen zu behandeln.
Genetik und Veranlagung: Wie stark sind die Ursachen erblich?
Viele Betroffene fragen sich, ob Akne inversa vererbt wird. Klar ist: In der Forschung gibt es Hinweise auf eine genetische Mitbeteiligung. Gleichzeitig spielen Umwelt, Reibung und Entzündungsreize im Alltag eine Rolle.
Wichtig ist der Blick nach vorn: Eine genetische Neigung kann das Risiko verschieben, aber sie erklärt nicht jeden Schub. Wer die Zusammenhänge kennt, kann Symptome früher einordnen und besser handeln.
Familiäre Häufung: was das Risiko erhöht
Bei einigen Familien zeigt sich eine familiäre Häufung Hidradenitis. Wenn Verwandte ersten Grades betroffen sind, steigt das Risiko Akne inversa messbar an. Das ist ein Grund, bei wiederkehrenden Knoten in Achsel, Leiste oder Gesäßfalte früher an HS zu denken.
Eine Familienanamnese kann auch im Arztgespräch helfen. Sie ersetzt keine Untersuchung, liefert aber einen wichtigen Hinweis, wenn Beschwerden immer wiederkehren.
Mögliche genetische Mechanismen: Barrierestörung und Entzündungsneigung
Fachleute diskutieren mehrere Wege, wie genetische Faktoren wirken könnten. Im Fokus stehen unter anderem Hautbarriere Gene, die beeinflussen, wie gut die Haut Reizstoffe abwehrt und Feuchtigkeit hält. Ist die Barriere leichter gestört, kann das Mikroklima in Hautfalten schneller kippen.
Auch die Verhornung im Haarfollikel und die Stärke von Entzündungsreaktionen können mit der genetische Veranlagung HS zusammenhängen. Dann wird ein Follikelverschluss wahrscheinlicher, und das umliegende Gewebe reagiert schneller gereizt.
| Baustein | Was sich verändern kann | Was Betroffene im Alltag häufig merken | Warum es für HS relevant ist |
|---|---|---|---|
| Hautbarriere | Durchlässigkeit und Reizschutz können schwanken (Hautbarriere Gene) | Rötung, Brennen, schnelleres Wundsein in Hautfalten | Mehr Reizung kann Entzündung in typischen Arealen begünstigen |
| Verhornung im Follikel | Keratin kann sich leichter stauen, Poren wirken schneller „zu“ | Feste Knoten, Druckgefühl, wiederkehrende Verstopfungen | Follikelverschluss gilt als früher Schritt in der Krankheitskette |
| Entzündungsantwort | Entzündung kann stärker oder länger anhalten | Längere Schubphasen, empfindliche Haut nach Abklingen | Chronische Aktivität kann wiederkehrende Läsionen fördern |
| Familiäre Muster | HS tritt in manchen Familien gehäuft auf (familiäre Häufung Hidradenitis) | Ähnliche Beschwerden bei Eltern, Geschwistern oder Kindern | Hinweis auf erhöhtes Risiko Akne inversa und Bedarf an früher Einordnung |
Warum Veranlagung nicht gleich „Schicksal“ bedeutet
Selbst wenn Akne inversa vererbt sein kann, heißt das nicht, dass sie zwangsläufig ausbricht. Gene wirken eher wie ein Verstärker: Sie verschieben die Wahrscheinlichkeit, aber sie sind nicht der einzige Auslöser. Genau deshalb lohnt es sich, Trigger zu beobachten und wiederkehrende Muster ernst zu nehmen.
Wer das eigene Risiko Akne inversa kennt, kann früher reagieren, ohne sich Schuld zu geben. Das entlastet viele: Eine genetische Veranlagung ist kein persönliches Versagen, sondern eine medizinische Ausgangslage.
Hormonelle Einflüsse und Lebensphasen: Pubertät, Zyklus, Schwangerschaft
Bei vielen beginnt Hormone Akne inversa in einer Phase, in der sich der Körper stark umstellt. Hormone beeinflussen Talg, Verhornung und die Reaktion des Immunsystems. Das kann die Haut in Arealen mit Reibung und Feuchtigkeit empfindlicher machen.
Gerade die Pubertät Hidradenitis suppurativa fällt auf, weil erste Knoten oft kurz nach Beginn der hormonellen Umstellungen auftreten. Dabei geht es selten um „ein“ Hormon. Häufig treffen mehrere Faktoren zusammen, etwa Veranlagung, Hautstress und Entzündungsneigung.
Viele Betroffene beobachten einen Zyklus Schub HS rund um bestimmte Tage. Hormonwechsel können die Hautbarriere und die Schmerzempfindlichkeit verändern. Ein kurzes Symptomtagebuch hilft, Muster zu erkennen, ohne vorschnell Ursachen festzulegen.
Das sind die neuesten Akne inversa Produkte
Auch Schwangerschaft Akne inversa verläuft sehr unterschiedlich. Manche erleben ruhigere Monate, andere mehr Aktivität, teils auch nach der Geburt. Wichtig ist die enge ärztliche Begleitung, weil nicht jede Behandlung in der Schwangerschaft oder Stillzeit passt.
Ein möglicher Baustein in diesem Bild ist die Androgene Entzündung. Androgene können indirekt Talgdrüsen und Follikelmilieu beeinflussen. Das erklärt, warum hormonelle Dynamik als Mitfaktor zählt, aber selten allein genügt.
| Lebensphase | Typische hormonelle Dynamik | Was viele in der Haut bemerken | Praktischer Fokus im Alltag |
|---|---|---|---|
| Pubertät | Anstieg von Sexualhormonen, aktivere Talgdrüsen | Erste schmerzhafte Knoten, mehr Reibungsreiz in Achseln und Leiste | Sanfte Reinigung, Reibung reduzieren, frühe Abklärung bei wiederkehrenden Läsionen |
| Zyklus | Schwankungen von Östrogen und Progesteron über den Monat | Zyklus Schub HS in einzelnen Phasen, stärkere Empfindlichkeit der Haut | Schub-Tage notieren, Kleidung weniger okklusiv wählen, Stress- und Schlafrhythmus prüfen |
| Schwangerschaft & Wochenbett | Starke Hormonverschiebungen, danach rascher Abfall | Schwangerschaft Akne inversa kann sich bessern oder verschlechtern, Veränderungen nach der Geburt möglich | Therapien ärztlich abstimmen, Hautpflege simpel halten, Warnzeichen früh ansprechen |
Wer Hormone Akne inversa einordnet, landet schnell bei einem Zusammenspiel: Veranlagung, Immunaktivität, Reibung, Gewicht und Rauchen können parallel wirken. Die hormonelle Lage liefert oft den Takt, aber nicht die ganze Melodie. So bleibt der Blick offen für mehrere Stellschrauben, statt nur eine zu suchen.
Risikofaktoren im Alltag: Rauchen, Übergewicht, Reibung und okklusive Kleidung
Im Alltag gibt es Einflüsse, die Schübe begünstigen können. Sie erklären den Verlauf oft mit, ersetzen aber keine ärztliche Diagnose. Auch schlanke Nichtraucher:innen können betroffen sein.
Rauchen und Entzündungsaktivität: mögliche Zusammenhänge
Beim Thema Rauchen Akne inversa geht es weniger um Schuld, sondern um Biologie. Nikotin und Rauchstoffe können die Hautbarriere belasten und Heilung verlangsamen. Das kann Entzündungen länger „am Laufen“ halten, besonders in empfindlichen Arealen.
Wer aufhört oder reduziert, beobachtet oft Veränderungen erst nach Wochen. Hilfreich ist, Schübe, Stress und Hautpflege kurz zu notieren, um Muster zu erkennen.
Übergewicht und Hautfalten: Druck, Wärme und Mikroverletzungen
Übergewicht HS Risiko hängt häufig mit mehr Hautkontakt zusammen. In Hautfalten stauen sich Wärme und Feuchtigkeit, und Druck entsteht beim Sitzen oder Gehen. Das begünstigt kleine Risse, gereizte Follikel und wunde Stellen.
Alltagstipp: Reibung senken, Haut trocken halten und auf sanfte Reinigung achten. Eine stabile Routine ist oft wichtiger als „perfekt“ zu sein.
Mechanische Belastung: Rasur, Sport, enge Kleidung und Haut-auf-Haut-Reibung
Mechanische Reize sind ein häufiger Reibung Trigger Hidradenitis. Beim Sport kommen Schweiß, Salz und Bewegung dazu. Auch wiederholtes Scheuern an Oberschenkeln oder in der Leiste kann die Haut dauerhaft stressen.
Problematisch ist oft enge Kleidung okklusiv, weil sie Wärme staut und die Haut aufweicht. Ebenso kann Rasur Achsel Leiste Entzündung fördern, wenn Mikroverletzungen entstehen oder Haare einwachsen. Sanftere Methoden und mehr Abstand zwischen Rasuren können die Haut beruhigen.
| Alltagsfaktor | Was in der Haut passieren kann | Woran man es oft merkt | Praktische Entlastung im Alltag |
|---|---|---|---|
| Rauchen Akne inversa | Barriere-Stress, langsamere Wundheilung, länger anhaltende Entzündung | Stellen bleiben länger gereizt, Abheilung zieht sich | Schrittweise reduzieren, Auslöser notieren, feste Hautpflege-Routine beibehalten |
| Übergewicht HS Risiko | Mehr Hautfalten, Wärme, Feuchtigkeit, Druck und Mikroverletzungen | Wundsein in Falten, Scheuern beim Gehen, nässende Reizung | Atmungsaktive Stoffe, Reibungszonen schützen, Haut nach Schwitzen zügig trocknen |
| Reibung Trigger Hidradenitis (Sport, Alltag) | Mechanische Reizung, Follikelstress, aufgescheuerte Haut | Rötung nach Bewegung, Brennen, Druckgefühl | Passform prüfen, Nähte vermeiden, Schweiß rasch abwaschen, Pausen bei aktiven Stellen |
| enge Kleidung okklusiv | Okklusion: Hitzestau, aufgeweichte Haut, mehr Reibung | Jucken, feuchte Areale, schnelleres Wundwerden | Lockere Schnitte, Baumwolle oder Funktionsstoffe mit guter Belüftung, Wechselkleidung dabeihaben |
| Rasur Achsel Leiste Entzündung | Mikroschnitte, eingewachsene Haare, irritierte Follikel | Sticheln nach der Rasur, kleine Knoten, Brennen | Sanfte Klinge, wenig Druck, Rasur nicht über entzündete Stellen, Haut danach beruhigen |
Mikrobiom und Bakterien: Ursache oder Verstärker der Erkrankung?
In entzündeten Arealen treffen viele Faktoren aufeinander: Reibung, Feuchtigkeit, Wundsekret und eine gereizte Hautbarriere. In diesem Umfeld verändert sich das Mikrobiom Akne inversa oft deutlich. Das kann Beschwerden verstärken, ohne dass es automatisch der Auslöser der Erkrankung ist.
Besiedlung vs. Infektion
Bei Hidradenitis suppurativa findet man häufig Bakterien HS in den betroffenen Regionen. Wichtig ist die Unterscheidung: Eine Besiedlung ist nicht dasselbe wie eine akute Infektion. Viele Keime nutzen nässende, warme Hautstellen als Lebensraum, besonders wenn Fistelgänge oder offene Stellen vorhanden sind.
Für den Alltag ist diese Einordnung entlastend: nicht ansteckend Hidradenitis bedeutet, dass man sich im Kontakt mit anderen Menschen nicht „überträgt“ wie bei klassischen Infektionskrankheiten. Geruch oder Sekret können zwar stark belasten, sagen aber allein nichts über Ansteckung aus.
Biofilme und chronische Entzündung
In wiederkehrend entzündeten Arealen wird auch ein Biofilm chronische Wunden diskutiert. Ein Biofilm ist eine Art Schutzschicht, in der Bakterien dichter zusammenleben und schwerer zu erreichen sind. Das kann erklären, warum manche Stellen lange aktiv bleiben oder nach kurzer Ruhe wieder aufflammen.
Biofilme passen vor allem zu Situationen, in denen Wunden immer wieder aufgehen, nässen und nur langsam abheilen. Dann verschiebt sich das lokale Gleichgewicht: Sauerstoff, pH-Wert und Nährstoffe ändern sich, und das Mikrobiom Akne inversa kann weiter aus dem Takt geraten.
Antibiotika und Resistenz
Antibiotika können in bestimmten Phasen sinnvoll sein, etwa wenn die bakterielle Komponente deutlich ist oder wenn eine entzündungsmodulierende Wirkung genutzt werden soll. Gleichzeitig spielt Antibiotika Resistenz HS eine große Rolle, weil wiederholte oder zu breite Therapien den Druck auf Keime erhöhen. Dann bleiben später weniger wirksame Optionen übrig.
| Einordnung im Alltag | Typische Hinweise | Was es für die Behandlung bedeutet |
|---|---|---|
| Besiedlung | Geruch, Sekret, wiederkehrendes Nässen; Bakterien HS im Abstrich ohne klare Infektzeichen | Wundmanagement, Hygiene, Reibung reduzieren; Antibiotika nur bei klarer Indikation |
| Akute Infektion | Zunehmende Rötung, starke Wärme, rasche Schmerzsteigerung, ggf. Fieber | Gezielte Abklärung und engmaschige Verlaufskontrolle, oft zeitlich begrenzte Antibiotikatherapie |
| Biofilm-Situation | Langsam heilende Areale, immer wieder aufbrechende Stellen; Verdacht auf Biofilm chronische Wunden | Kombination aus lokaler Therapie, Wundreinigung und passender Systemtherapie; Resistenzrisiko mitdenken |
Damit Therapien passen, braucht es eine klare Sprache: Geht es um Entzündung, Besiedlung oder Infektion? Diese Unterscheidung hilft auch, die Sorge vor Ansteckung einzuordnen, denn nicht ansteckend Hidradenitis bleibt ein zentraler Punkt im Umgang mit der Erkrankung.
Frühe Anzeichen und typische Entwicklung: Von Knoten zu Abszessen und Fisteln
Akne inversa erste Anzeichen wirken oft harmlos, sind es aber nicht. Viele Betroffene spüren wiederkehrende, tief sitzende Schwellungen, die eher wie „Knoten unter der Haut“ wirken als wie Pickel. Typisch ist, dass sie an denselben Stellen erneut auftreten.
Häufig zeigen sich schmerzhafte Knoten Achsel Leiste, manchmal auch in der Gesäßfalte oder im Intimbereich. Die Haut darüber ist warm, gerötet und druckempfindlich. Reibung, Schwitzen und enge Kleidung können die Beschwerden zusätzlich anfeuern.
Entzündet sich ein Knoten stärker, kann daraus ein Abszess Fistelgang als nächster Schritt im Geschehen entstehen. Ein Abszess sammelt Eiter, spannt und kann sich spontan öffnen, mit übel riechendem Sekret. Nach kurzer Ruhe folgt bei vielen ein erneuter Schub am gleichen Ort.
Bei wiederholten Entzündungen kann das Gewebe unter der Haut beschädigt werden. Dann bilden sich Gänge, die einzelne Herde verbinden und dauerhaft nässen können. Diese Entwicklung passt in die HS Stadien, die Ärztinnen und Ärzte zur Einordnung von Ausmaß und Struktur nutzen.
| Beobachtung im Alltag | Was es bedeuten kann | Warum es wichtig ist |
|---|---|---|
| Wiederkehrende, tiefe Knoten an derselben Stelle | Akne inversa erste Anzeichen mit typischem Muster | Frühe Abklärung kann unnötige Schübe und Gewebeschaden begrenzen |
| Schmerzhafte Knoten mit starker Druckempfindlichkeit | Aktive Entzündung, oft schmerzhafte Knoten Achsel Leiste | Schmerz und Bewegungseinschränkung sind Warnsignale, nicht „normal“ |
| Spontanes Öffnen, Eiter, wiederkehrendes Nässen | Abszess; bei Wiederholung Risiko für Abszess Fistelgang | Dauerhafte Feuchtigkeit begünstigt Reizung, Geruch und neue Entzündung |
| Derbe Stränge, Einziehungen oder harte Narben | Hinweise auf fortgeschrittenere HS Stadien | Narben können spannen, die Haut beweglicher Areale einschränken |
Der Verlauf Hidradenitis ist oft schubweise und nicht linear. Gerade die Wiederkehr an typischen Arealen gilt als starkes Signal, die Haut früh dermatologisch ansehen zu lassen. So lässt sich besser einschätzen, welche Muster bereits vorliegen und wie aktiv die Entzündung ist.
Warum Akne inversa chronisch wird: Trigger, Schübe und Narbenbildung
Dass Akne inversa chronisch wird, liegt oft an einem Kreislauf in der Haut. Ein Haarfollikel verstopft, reißt auf, und das Immunsystem reagiert stark. Das Gewebe schwillt an, es entsteht Druck, und Entzündung kann sich ausbreiten. Mit der Zeit baut der Körper um: Es bleiben derbe Areale zurück, die neue Probleme begünstigen.
Viele Betroffene erleben, dass HS Schübe Trigger selten nur eine einzige Ursache haben. Reibung, enge oder okklusive Kleidung und Schwitzen können die Haut reizen, vor allem in Achseln und Leiste. Rauchen, höheres Körpergewicht, hormonelle Phasen und Stress gelten als mögliche Verstärker. Treffen mehrere Faktoren zusammen, steigt die Chance auf einen neuen Schub.
Mit Fortschreiten werden Narbenbildung Fisteln zu einer Art „Entzündungsarchitektur“. Tunnel und Fistelgänge verändern Abflusswege, Feuchtigkeit staut sich leichter, und Bakterien können sich in Nischen halten. Narbengewebe ist weniger elastisch, wodurch mehr Zug und Druck entsteht. So kann die Erkrankung leichter erneut aufflammen und schwerer zu kontrollieren sein.
Um Rückfall vermeiden zu können, zählt vor allem frühes Handeln. Eine zeitnahe Diagnose und ein konsequentes Krankheitsmanagement HS können die Schubfrequenz senken und bleibende Schäden begrenzen. Wer wiederkehrende, schmerzhafte Knoten in Achsel, Leiste oder Intimbereich bemerkt, sollte das in Deutschland dermatologisch abklären lassen. Je früher die Behandlung passt, desto besser lassen sich Schübe und Narben eindämmen.
FAQ
Was ist Akne inversa (Hidradenitis suppurativa) – und warum ist das keine „normale Akne“?
Akne inversa, auch Hidradenitis suppurativa (HS) genannt, ist eine chronisch-entzündliche Hauterkrankung. Sie entsteht nicht wie Acne vulgaris vor allem durch typische Mitesser im Gesicht, sondern durch tiefe Entzündungen an Haarfollikeln. Häufig bilden sich schmerzhafte Knoten, Abszesse, Fistelgänge und Narben.
Welche Körperstellen sind bei Akne inversa besonders häufig betroffen?
Typisch sind Areale mit Wärme, Feuchtigkeit und Haut-auf-Haut-Reibung. Dazu zählen Achselhöhlen, Leiste, Intimbereich, Anogenitalregion sowie die Gesäßfalte. Auch die Innenseiten der Oberschenkel können betroffen sein.
Wie entsteht Akne inversa im Körper – was ist der Startpunkt?
Meist beginnt der Prozess im Haarfollikel durch eine Verhornungsstörung. Dabei verengt oder verstopft der Follikel, Talg und Keratin stauen sich. Das kann den Druck erhöhen und eine Entzündung in Gang setzen.
Was passiert bei einer Follikelruptur, und warum tut das so weh?
Reißt die Follikelwand, gelangen Keratin, Talg und Zellbestandteile ins umliegende Gewebe. Das Immunsystem reagiert darauf wie auf ein Alarmsignal. Es kommt zu Rötung, Schwellung, Wärme, starken Schmerzen und teils zu Eiteransammlungen.
Welche Rolle spielen Talgdrüsen und Schweißdrüsen bei HS?
Im Zentrum steht der Haarfollikel, nicht die Schweißdrüse als alleinige Ursache. Talg und Keratin können die Pfropfbildung im Follikel fördern. Schweiß, Feuchtigkeit und Mazeration in Hautfalten können die Hautbarriere zusätzlich reizen und Entzündungen verstärken.
Welche Symptome sind typisch – und woran erkennt man frühe Anzeichen?
Früh zeigen sich wiederkehrende, druckschmerzhafte Knoten, oft tief unter der Haut. Sie treten meist in Achseln, Leisten, Po-Falte oder im Intimbereich auf. Werden daraus Abszesse, kann es zu Nässen, Geruch und wiederholtem Auftreten an derselben Stelle kommen.
Wie entwickeln sich Fistelgänge und Narben bei Akne inversa?
Wiederholte Entzündungen schädigen das Gewebe und begünstigen tunnelartige Verbindungen unter der Haut. Diese Fistelgänge können Entzündungen miteinander verbinden und die Heilung erschweren. Mit der Zeit entstehen derbe Narben und Stränge, die auch Bewegung einschränken können.
Warum wird Akne inversa häufig chronisch und kommt in Schüben?
Die Erkrankung kann sich durch einen Kreislauf aus Verschluss, Ruptur, Entzündung und Gewebsumbau selbst verstärken. Narbengewebe verändert die Hautmechanik und kann Abfluss und Reibung ungünstig beeinflussen. Dadurch treten Schübe oft rezidivierend auf.
Ist Akne inversa ansteckend?
Nein, HS gilt nicht als ansteckende Infektionskrankheit. Bakterien können entzündete Areale zwar sekundär besiedeln, das ist aber meist nicht der Startpunkt. Wichtig ist die Unterscheidung zwischen Besiedlung und echter Infektion.
Welche Bedeutung hat das Mikrobiom – und was sind Biofilme?
Das Hautmikrobiom kann bei chronisch entzündeten, nässenden Arealen eine Rolle als Verstärker spielen. Diskutiert werden Biofilme, also bakterielle Gemeinschaften, die sich an Oberflächen halten und Heilung erschweren können. Das erklärt, warum Beschwerden trotz Hygiene nicht einfach verschwinden.
Können Antibiotika helfen, und warum ist das Resistenz-Thema wichtig?
Antibiotika können je nach Situation sinnvoll sein, etwa bei bakterieller Beteiligung oder auch wegen entzündungsmodulierender Effekte. Gleichzeitig kann ein häufiger oder ungezielter Einsatz Resistenzen fördern. Deshalb ist eine klare dermatologische Diagnose und Verlaufskontrolle entscheidend.
Welche Rolle spielt das Immunsystem bei Hidradenitis suppurativa?
Nach Follikelverschluss und Ruptur kann das Immunsystem übermäßig reagieren. Entzündungsbotenstoffe und Immunzellen treiben Schmerz, Schwellung und Eiterbildung an. Bei einigen Betroffenen hat die Entzündung auch eine systemische Komponente und kann mit Komorbiditäten zusammenhängen.
Ist Akne inversa erblich – und was bedeutet familiäre Häufung?
In manchen Familien tritt HS häufiger auf, was für eine genetische Mitbeteiligung spricht. Gene können Hautbarriere, Verhornung und Entzündungsneigung beeinflussen. Eine Veranlagung erhöht das Risiko, bedeutet aber nicht, dass der Verlauf festgelegt ist.
Welche hormonellen Einflüsse sind bekannt (Pubertät, Zyklus, Schwangerschaft)?
HS beginnt häufig nach der Pubertät, wenn sich Hormone verändern. Manche Betroffene beobachten zyklusabhängige Schübe, was zu hormoneller Entzündungsmodulation passen kann. In der Schwangerschaft kann sich der Verlauf verbessern oder verschlechtern, daher ist ärztliche Begleitung wichtig.
Welche Alltagsfaktoren können Schübe fördern – zum Beispiel Rauchen, Übergewicht oder enge Kleidung?
Rauchen wird häufig als Verstärker diskutiert, unter anderem wegen höherer Entzündungsaktivität und schlechterer Wundheilung. Übergewicht kann Reibung, Wärme, Feuchtigkeit und Okklusion in Hautfalten erhöhen. Enge, nicht atmungsaktive Kleidung, Sport mit Scheuern oder Rasur mit Mikroverletzungen können ebenfalls Trigger sein.
Ist Stress ein Auslöser für Akne inversa?
Stress gilt nicht als alleinige Ursache, kann aber als Verstärker wirken. Er kann Schlaf, Schmerzempfinden, Entzündungsregulation und Verhalten wie Rauchen beeinflussen. Viele Betroffene erkennen Stress als Teil ihres persönlichen Triggerprofils.
Warum reicht eine „Pickelbehandlung“ bei Akne inversa oft nicht aus?
HS betrifft tiefe Strukturen rund um den Haarfollikel und führt zu Abszessen, Fisteln und Narben. Oberflächliche Produkte gegen Mitesser oder klassische Akne im Gesicht greifen hier meist zu kurz. Entscheidend ist eine korrekte Einordnung durch Dermatologie, besonders bei wiederkehrenden Knoten in typischen Arealen.
Wann sollte man mit Verdacht auf Akne inversa ärztlich abklären lassen?
Wenn schmerzhafte Knoten oder Abszesse wiederholt in Achsel, Leiste, Intimbereich oder Gesäßfalte auftreten, ist eine frühe Abklärung sinnvoll. Je früher die Diagnose steht, desto besser lassen sich Schubfrequenz und Narbenbildung oft begrenzen. Auch eine Familienanamnese kann ein wichtiger Hinweis sein.